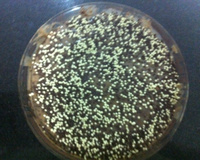
Bolo de Ovomaltine

50min
Ingredientes (10 porções)
-

-

-

-

-
1 xícara de ovomaltine em flocos
-

-

-

-

-
3 colheres cheias de ovomaltine
Modo de preparo
Modo de preparo :
- 1
No liquidificador, bater os ovos, açúcar, óleo, água morna e ovomaltine em flocos até que misture tudo.
- 2
Em um recipiente coloque a mistura do liquidificador e acrescente aos poucos o trigo. Depois o fermento.
- 3
Untar a forma com margarina e nescau.
- 4
Colocar no forno por 50 minutos.
- 5
Para fazer a cobertura, misture a margarina, o leite condensado e o ovomaltine numa panela até começar a borbulhar. Só colocar sobre o bolo.